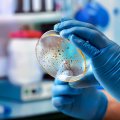

Geen producten in de winkelwagen.
Dit zijn de 10 grootste CO2 vervuilers van Nederland
Nick Gosselaar10 december 2024
CO2 uitstoot is niet goed voor onze planeet en zorgt voor klimaatverandering. Het is dus de hoogste tijd dat dit omlaag wordt gebracht, maar welke bedrijven in Nederland zijn nou verantwoordelijk voor de meeste CO2 uitstoot? In dit artikel zetten we de 10 grootste CO2 uitstoters van ons land op een rij.
- Volgens Milieudefensie komt 71 procent van de wereldwijde CO2 uitstoot sinds 1988 van slechts 100 bedrijven.
- In Nederland zijn de 30 grootste CO2 uitstoters verantwoordelijk voor maar liefst 40 procent van de totale CO2 uitstoot van ons land.
- In ons land wordt er relatief veel CO2 uitgestoten in Rotterdam, IJmuiden en Eemsmond.
- Veel bedrijven hebben beloofd om hun CO2 uitstoot in de komende jaren te verminderen, dus laten we hopen dat deze top 10 in de komende jaren een flinke verbetering laat zien.
Top 10 grootste CO2 uitstoters van Nederland
Uit cijfers van de Nederlandse Emissieautoriteit blijkt dat de volgende tien bedrijven de grootste CO2 uitstoters van Nederland zijn:
1. Tata Steel IJmuiden
Het staalbedrijf Tata Steel in IJmuiden staat op de eerste plek in deze top 10 grootste CO2 uitstoters van Nederland. Het staalproductiebedrijf stootte in 2020 maar liefst 5,7 miljoen ton CO2 uit en is daarmee de allergrootste CO2 vervuiler van ons land.
2. Shell Nederland Raffinaderij
Op de tweede plek in de top 10 grootste CO2 uitstoters van Nederland staat Shell. De oliemaatschappij stootte in 2020 ruim 4,1 miljoen ton CO2 in ons land uit. Royal Dutch Shell heeft daarnaast de twijfelachtige eer om wereldwijd een van de allergrootste CO2 uitstoters te zijn. Het bedrijf is volgens Active Sustainability verantwoordelijk voor 1,7 procent van alle CO2 uitstoot en staat daarmee in de top 10 bedrijven die wereldwijd het meeste CO2 uitstoten. Daar kunnen we als Nederlanders echt “trots” op zijn.
Dit jaar won Milieudefensie nog een rechtszaak tegen Shell. De rechter bepaalde dat het oliebedrijf verplicht is om de CO2 uitstoot in 2030 met netto 45 procent te verminderen ten opzichte van het niveau van 2019. Dat was nogal een klap voor Shell, want het bedrijf dacht zelf aan een 20 procent vermindering. Shell is wel in beroep gegaan tegen de uitspraak van de rechter, dus de verplichting staat (nog) niet vast. Wordt ongetwijfeld nog vervolgd.

3. Vattenfall Power Velsen
De nummer drie van deze top 10 is Vattenfall Power in Velsen. Deze energiecentrale stootte in 2020 ongeveer 3,4 miljoen ton CO2 uit in Nederland. Deze centrale staat overigens vlak bij Tata Steel, dus in dat gebied wordt goed gewerkt aan de CO2 uitstoot van ons land. Met een derde plek in deze top 10 is Vattenfall al goed vertegenwoordigd, maar de energiecentrale in Velsen is niet de enige Vattenfall contributie aan deze top 10.
4. Uniper Centrale Maasvlakte
Op de vierde plek in deze top 10 grootste CO2 uitstoters van Nederland staat wederom een energiecentrale. Deze plek wordt namelijk in beslag genomen door Uniper Centrale Maasvlakte, dat in 2020 net wat minder dan 3,4 miljoen ton CO2 uitstootte in Nederland. Dat is al best veel en samen zijn alle Nederlandse kolencentrales verantwoordelijk voor maar liefst 7 procent van de totale CO2 uitstoot van ons land.
In de toekomst zal de Uniper Centrale Maasvlakte waarschijnlijk geen CO2 meer uitstoten. In 2019 werd door de Tweede Kamer een verbod ingesteld op kolencentrales. Dat verbod gaat vanaf 2030 in.
Overigens kan het zelfs al eerder gebeuren dat deze kolencentrale sluit, want vorig jaar gaf de toenmalige minister Wiebes van Economische Zaken en Klimaat aan dat hij eventueel de kolencentrales eerder wilde sluiten om zo aan de klimaatdoelen van Urgenda te voldoen. Misschien dat de kolencentrales in Nederland dus in de nabije toekomst niet meer in deze top 10 staan.
5. ESSO Raffinaderij Rotterdam
De ESSO Raffinaderij in Rotterdam staat op de vijfde plek in deze top 10 grootste CO2 uitstoters van Nederland. ESSO stoot weliswaar iets minder uit dan concurrent Shell, maar was in 2020 nog steeds verantwoordelijk voor een uitstoot van ruim 2,6 miljoen ton CO2.
6. RWE Eemshaven Centrale
Op de zesde plek in deze top 10 grootste CO2 uitstoters van Nederland staat de Eemshavencentrale in Groningen. Deze centrale was in 2020 verantwoordelijk voor ongeveer 2,5 miljoen ton CO2 uitstoot.
Een zesde plek is niet echt iets om trots op te zijn, maar de Eemshavencentrale in Groningen stond nog niet zo lang geleden op de eerste plek in deze top 10. Tussen 2016 en 2018 stootte de centrale namelijk jaarlijks ongeveer 8 miljoen ton CO2 uit en was het bedrijf dus nog een vele grotere CO2 uitstoter. Door verduurzaming van het bedrijf en de gevolgen van de coronacrisis is de uitstoot van het bedrijf echter drastisch omlaag gegaan. Dus zo zie je maar dat je binnen enkele jaren flinke verbetering voor elkaar kan krijgen!
De toekomst van Eemshaven is overigens onzeker, want ook dit is een kolencentrale die uiterlijk in 2030 moet worden gesloten. Dat is overigens best zonde als je bedenkt dat het bedrijf pas in 2015 in werking is gegaan. De bouw was ook geen goedkope grap, want de centrale kostte ongeveer 1-2 miljard euro.

7. Vattenfall Magnum Centrale Eemsmond
De Vattenfall Magnum Centrale staat op de zevende plek in de top 10 grootste CO2 uitstoters van Nederland. Deze centrale – die vlak bij de RWE Eemshaven Centrale staat – stootte ruim 2,2 miljoen ton CO2 in 2020 uit.
8. Energie Productie Clauscentrale
Op de achtste plek in deze top 10 grootste CO2 uitstoters van Nederland staat de Energie Productie Clauscentrale. Deze elektriciteitscentrale in Maasbracht stootte ruim 2,1 miljoen ton CO2 in 2020 uit.
De Clauscentrale is een relatief nieuw gezicht in deze top 10. In de periode 2015-2018 stootte het bedrijf nagenoeg niks uit omdat het tijdelijk gesloten was. Onlangs is de centrale weer begonnen met het produceren van elektriciteit en dat heeft meteen geleid tot een plek in deze top 10.
9. BP Raffinaderij Rotterdam
Dat olieraffinaderijen veel CO2 uitstoten is bepaald geen geheim, dus het is geen verrassing dat ook de BP Raffinaderij in Rotterdam in deze top 10 staat. De Britse raffinaderij stootte in 2020 ruim 2 miljoen CO2 uit in ons land en staat daarmee op de negende plek in deze top 10 grootste CO2 uitstoters van Nederland.
10. Enecogen
Op de tiende plek staat weer een energiecentrale en die eer gaat naar Enecogen. De energiecentrale van Eneco in Rotterdam stootte in 2020 ongeveer 1,9 miljoen CO2 uit en krijgt daarmee de twijfelachtige eer om deze top 10 grootste CO2 uitstoters van ons land af te sluiten.
Aanvullend
Wat is MIC, is dit bedreigend voor de mensheid?
Sandra Vernon26 augustus 2021De ontwikkeling van de huizenmarkt door de jaren heen
Sandra Vernon23 augustus 2021POLL: Geloof jij dat de top 10 grootste CO2-uitstoters in Nederland hun uitstoot significant zullen verminderen voor 2030?
Ja9.1%
Nee72.7%
Misschien18.2%
📊 Bekijk resultatenVerberg resultaten

Plaats een reactie